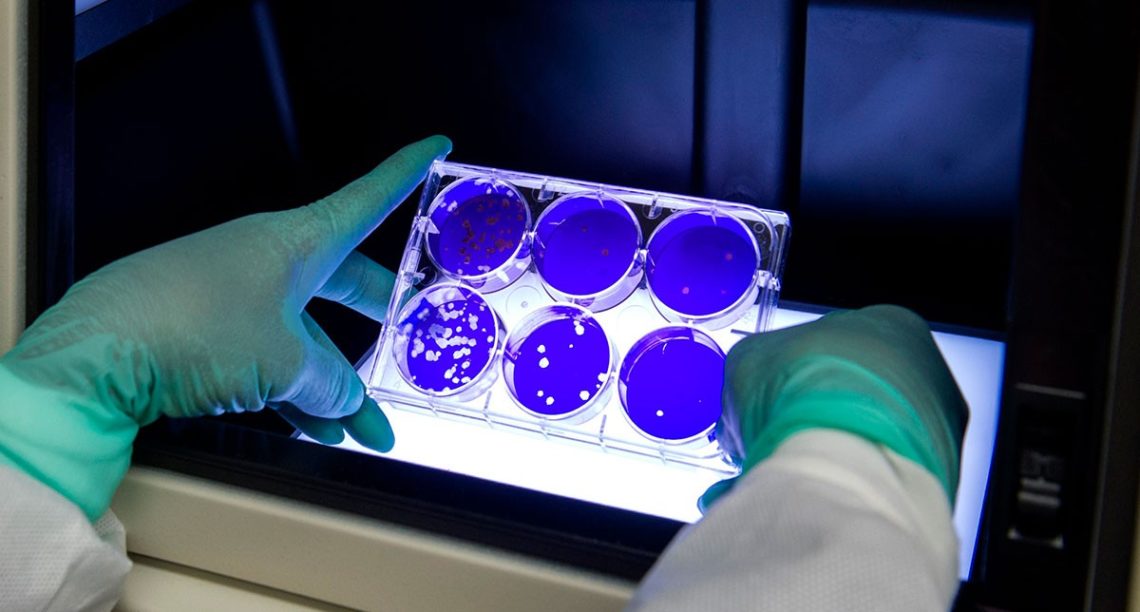
Pendekatan Sains dan Kesempatan Menarik dalam Pandemi Corona

Covid-19 harus jadi momen inspiratif bagi para siswa sekolah untuk berimajinasi menjadi ahli biologi, micro-biology, virologi, science-enterpreneur, hingga social scientist di masa depan.
Lebih kurang dua bulan ini, saya tak terlalu mengikuti berita apapun soal Covid-19. Bukan apa-apa, saya hanya bosan membaca berita-berita yang sesungguhnya imitasi dari berita yang sama. Dan menurut saya, itu kurang bagus karena sekadar memicu efek psikosomatik bagi para pembaca.
Dalam konsep Law of Attraction (LoA) atau konsep New Thought-nya William Atkinson, pikiran adalah energi luar biasa yang bisa mendekatkan kita pada apa yang kita pikirkan. Atau, saat kita memikirkan sesuatu, ada daya magnetis yang mengantar kita pada sesuatu itu.
Jika setiap hari kita dijejali informasi perihal kecemasan akan Covid-19, misalnya, bukankah setiap itu pula kita akan memikirkan dan mecemaskannya? Dan bukankah proses cemas — yang diawali dengan turunnya imun tubuh — justru memicu hal buruk?
Oke, biar tak terlalu terkesan liberal, mungkin istilah Law of Attraction ini bisa diubah menggunakan konsep Ilahiah berupa Husnudzon atau berprasangka baik pada ketetapan Tuhan. Nah, betapa sulitnya berprasangka baik kalau sering membaca berita mencemaskan?
Karena itu, di tengah maraknya berita soal Covid-19, kecenderungan tak mengikuti berita adalah opsi yang baik. Setidaknya, sekadar tahu dan tak banyak tahu. Karena kian banyak pengetahuan, justru mengantar pada kecemasan.
Dan pandangan saya sedikit fresh ketika semalam, founder Pustaka Bergerak Indonesia, Nirwan Ahmad Arsuka, mem-forward sebuah tulisan menarik dari Direktur Centre for Strategic and International Studies (CSIS) Jakarta, Philip Vermonte.
Philip menulis tulisan yang amat detail, realistis, menggugah, tapi amat sederhana dan mudah dipahami siapapun. Sebuah tulisan yang membuat saya membatin: harusnya tulisan semacam ini muncul di awal-awal masa pandemi.
Dalam pembukaan tulisannya, Philip mengatakan: ada kesempatan besar di balik keberadaan Covid-19. Sebuah kesempatan baik yang harus bisa dimanfaatkan seluruh komponen masyarakat. Terutama siswa, guru dan orang tua di rumah.
Selain menebar konsep Psikologi Positif ala Martin Seligman sejak pembukaan paragraf, tulisan Philip punya kesan berbeda. Khususnya di tengah maraknya tulisan berorientasi kecemasan soal Covid-19. Ia mendekonstruksi kecemasan, namun tetap realistis.
Ada kesempatan besar untuk mendekatkan sains di tengah Corona.
Kesempatan besar itu, menurut Philip adalah pendekatan sains pada siswa-siswa sekolah. Ya, ini momen terbaik para siswa mengenal pendekatan sains. Terlebih, ada contoh nyata sekaligus pengalaman pahit perihal Covid-19, yang sangat berpotensi teringat lama dalam pikiran.
Adanya Covid-19, harusnya jadi momentum para guru dan orang tua untuk memicu-munculkan minat para siswa sekolah TK, SD, SMP, hingga SMA terhadap sains. Mengingat, Covid-19 bisa didekati dan dipelajari melalui ranah sains.
Sayangnya, seperti yang dikemukakan Philip, kesempatan baik tersebut rentan terbuang sia-sia karena pengatur kebijakan tak mengandalkan sains sejak awal. Sehingga di mata para pelajar kita, Covid-19 hanyalah monster ghaib yang berbahaya.
“Tidak kelihatan ada dorongan bagi siswa-siswa sekolah kita secara terbuka dari para pejabat kita. Seolah-olah, siswa-siswa kita saat ini tidak memperhatikan dan tidak mengikuti bagaimana negara ini dipandu oleh para pemimpin hari ini dalam menghadapi COVID-19 ini.” Begitu kata Philip.
Ya, memang benar. Para siswa sekolah, saat ini hanya menjadi objek yang diliburkan. Atau bahasa kalemnya diayomi dan diamankan. Tanpa ada dorongan untuk “mempelajari” dan mengetahui apa itu Covid-19.
Padahal seharusnya, ini momen terbaik untuk membangun imajinasi tentang ahli biologi, micro-biology, virologi, science-enterpreneur, hingga social scientist di kepala para siswa dan pelajar kita. Agar Covid-19 tak sekadar monster menakutkan belaka.
Di tengah pandemi ini, tak ada sains di mata publik. Yang ada hanya gelagat dan trik-trik politik, kalau tidak begitu ya kerugian bisnis dan bagaimana tetap menjalankan bisnis. Tak ada sains di Covid-19.
Pandemi seolah hanya kecemasan orang-orang dewasa. Dan anak-anak cukup “diamankan” saja. Sementara imajinasi subur yang harusnya dikenalkan pada sains, ditumpulkan dengan tanpa adanya dorongan apa-apa terhadap pendekatan sains.
Para siswa cukup “diamankan” dengan diliburkan di rumah. Sementara imajinasinya terpaku pada gadget dan game online yang seolah mendapat legitimasi untuk bermain sepuasnya asal tak kemana-mana.
Kelak, puluhan tahun saat para siswa itu sudah seumuran pemimpin yang saat ini, misal ada pandemi Corona lagi, apa yang akan mereka lakukan selain meminta anak-anak di bawah generasinya untuk di rumah dan main game saja?
Itu jelas terjadi. Sebab, jika saat ini yang mereka kerjakan sekadar main game dan melihat gelagat politis orang-orang dewasa, kelak saat mereka menjadi pemimpin dan terjadi pandemi lagi, imajinasi mereka tak jauh-jauh dari game dan gelagat politis.
Tapi jika saat ini mereka berada di rumah sambil dimotivasi dan didorong untuk belajar dan mengenal semesta sains terhadap Covid-19, kelak saat menjadi pemimpin, mereka sudah tahu apa yang harusnya dilakukan. Dorongan dan motivasi, dalam hal ini, penting.
Membangun imajinasi dengan unsur Positif Psikologi ala Martin Seligman amat penting. Agar para siswa tak hanya cemas —- lalu untuk menghibur diri main game online sepuasnya. Tapi lebih pada waspada dan punya kemauan untuk mempelajari sains.
Setidaknya, imajinasi tentang ahli biologi, micro-biology, virologi, science-enterpreneur, hingga social scientist di masa depan, membuat mereka bersemangat mempelajari sains. Dan dengan cara itu, konsep Law of Attraction pun bisa menggerakkan daya magnetis pada perihal yang lebih baik.